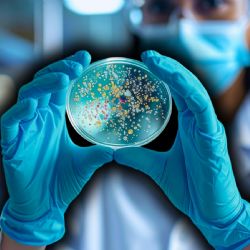
Científicos descubren superbacteria milenaria en el hielo que resiste a 10 antibióticos

Ciencia y Tecnología
¿Se cayó? Reportan falla masiva en la red social X hoy 16 de febrero
Este lunes, el sitio especializado Down Detector confirmó el pico de fallas en la red social propiedad del magnate Elon Musk.
Motorola Edge 60 fusion: Especificaciones y precio con descuento en febrero de 2026
Este dispositivo móvil tiene resistencia militar IP68/IP69, cámara Sony de 50 MP y 8GB de RAM física expandibles con IA.
¿Qué sentimos al partir? La nueva teoría científica de la consciencia después de la muerte
En un nuevo estudio, expertos sugieren que el fallecimiento es un proceso gradual y potencialmente "negociable".
VIDEO | ¿Es él? El rostro de Jesucristo por IA basado en el Santo Sudario
Una inteligencia artificial recrea el rostro hiperrealista del hombre de la Sábana Santa basándose en patrones y marcas traumáticas del lienzo de Turín.
Adiós al misterio: Todo lo que sabemos del Samsung Galaxy S26 y su IA
La compañía surcoreana anunció que el Galaxy Unpacked será el 25 de febrero en San Francisco, Estados Unidos.
Google lanza alerta: Más de mil millones bajo vulnerabilidad en celulares Android
Google y Samsung advierten sobre ataques de spyware en dispositivos móviles obsoletos.
¿Adiós a la chamba? Este país se prepara para el impacto de la IA en el mercado laboral
Un informe del Fondo Monetario Internacional advierte que el 20 por ciento de los trabajadores de una nación podría ser desplazado por la inteligencia artificial (IA).
Rebaja de febrero 2026: El Xiaomi Redmi Note 15 Pro+ 5G baja su precio en la tienda oficial
Este dispositivo móvil incluye cámara de 200MP, batería de 6500 mAh y regalos como la Smart Band 10 y Buds 6.